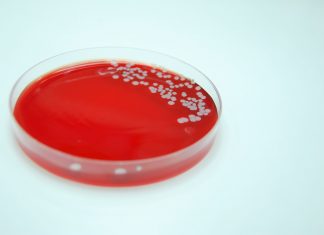
Nasal swab offers hope for reducing vancomycin use Bacterial Culture of Staphylococcus aureus

Lockdowns and vaccine confusion plague nation
As Australia sits on the knife’s edge of a national COVID-19 outbreak, authorities are scrambling to bolster vaccination rates.
Nasal swab offers hope for reducing vancomycin use
A study has found a pharmacy-driven protocol using nasal swabs to assess methicillin‑resistant Staphylococcus aureus (MRSA) in pneumonia cases holds promise for reducing unnecessary...
The pain of uncertainty: Managing pain without codeine
With over-the-counter (OTC) codeine products being upscheduled, pharmacists and pharmacy staff need to review and understand every patient’s pain. In doing so, there’s an...
A simple way to improve pharmacist-patient interactions
Checking technicians would allow pharmacists to spend more time on patient-focused activities in both community and hospital pharmacy settings, New Zealand research has found.
Based...
Quick Q&A with Katherine Higgins MPS
Jennifer Cooke, the Editor of Australian Pharmacist, talks with Katherine Higgins, a pharmacist in South Perth, Western Australia.
GP Pharmacists change views on pharmacy scope of care
Having a pharmacist in a general practice can be a powerful tool for changing other healthcare practitioners' attitudes towards pharmacy scope of care, a...